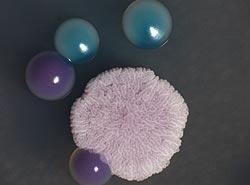

Mikroargazkiko III. Lehiaketa Biomedikuntzan
Ebazpena Mikroargazkiko III. Lehiaketa Biomedikuntzan
Lehenengo argitaratze data: 2011/12/13
(SGIker) Ikerkuntzarako zerbitzu orrokorretatik,"Mikroargazkiko III. Lehiaketa Biomedikuntzan" aurkezturiko; argazki bilduma; argitaratzen dugu.
Epaimahaiaren erabakiaren arabarera, sarituriko lehiakideak honako hauek dira:
1.Saria
Sergio Seoane Parra bere egintzagatik: "Todos los días sale el sol"
2.Saria
Cristina Marcos Arias bere egintzagatik: "La huella de Cándida"
3.Saria
Asier Ruiz Núñez bere egintzagatik: "El abrazo"
Egintzak baloratzeko beteriko irizpideak honako hauek izan dira
- Inpaktu bisuala
- Zailtasun teknikoa
- Emaitza zientifikoa
- Originaltasuna eta estilo didaktikoa
Oraingo edizioaren epaimahaia hurrengo pertsonaz osaturik egon da
- Juan Aréchaga (Histologia eta zelula biologia sailaren katedraduna, Mikroskopia analitikoa eta bereizmen handikoa Biomedikuntzan )
- Alberto Vicario (Genetika, antropologia fisika eta animalien fisiologia sailaren irakasle titularra)
- Alberto Pérez (Neurozientzien sailaren irakasle titularra)
- Álvaro Villaroel (CSIC Ikertzailea, Biofisika unitatea)
- Jorge Navarro (Multimediako Teknikari Espezialista, SGIker)
Oso aurki, UPV/EHU-k gure eskura jartzen dituen baliabideak erabiliz, sariak entregatzeko jendaurreko ekintza argitaratuko dugu.
Lehiaketan parte hartu duten pertsonen ahalegina eskertzeko aukera honetaz baliatzen gara (ikasleak, ikertzaileak, doktoreak… ) eta argazki bilduma ikustera gonbidatzen zaituztegu jasotako argazkien goiko maila eta kalitatea ikusteko.